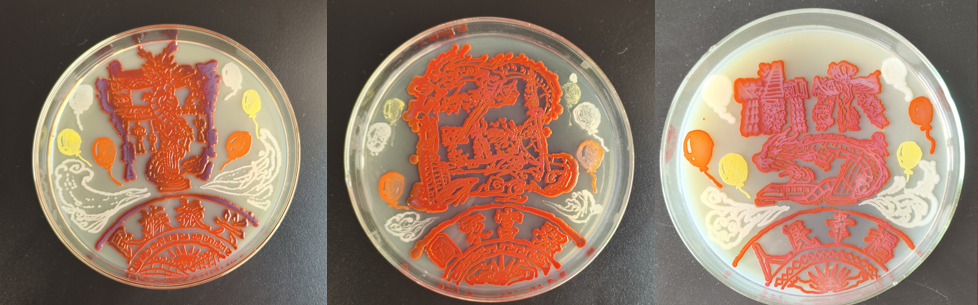

12月14日,由辽宁省教育厅主办、沈阳药科大学与沈阳城市学院共同承办的“2025年辽宁省普通高等学校本科大学生微生物科学与艺术设计大赛暨辽宁省第二届微生物与人体健康学术研讨会”在沈阳药科大学沈阳主校区图书馆第一学术报告厅举行。沈阳城市学院校党委常委、副校长孟娜,我校党委常委、副校长路金才出席开幕式。生命科学与生物制药学院党政负责人、创新创业学院相关负责同志参加开幕式。大赛由生命科学与生物制药学院张怡轩主持。
此次大赛汇集了东北大学、中国医科大学、大连海洋大学、大连大学、大连民族大学、沈阳农业大学、沈阳化工大学、沈阳城市学院、辽东学院、辽宁工程技术大学、锦州医科大学、渤海大学、沈阳药科大学等30所高校队伍,参赛作品累计582幅。

路金才在开幕式上致辞。他代表学校向参加本次大赛及研讨会的各位嘉宾及兄弟院校的师生表示诚挚欢迎,对大赛评委及组委会人员表示衷心感谢。他介绍了学校的发展沿革、办学特色、学科专业建设及人才培养成果等。他表示,本次大赛是沈阳药科大学与沈阳城市学院发挥各自学科优势、共同探索创新人才培养模式的有益尝试。他希望,未来共同努力,将这一赛事打造成一个覆盖范围更广、学术内涵更深、艺术特色更为鲜明的高水平竞赛平台。

孟娜在致辞时,对本次大赛及研讨会的召开表示祝贺。她表示,本次大赛是沈阳药科大学与沈阳城市学院充分整合两校特色资源、发挥各自学科优势,共同探索跨校协作、融合创新的育人新模式的重要实践。沈阳城市学院将以共同承办省内重要学科竞赛为契机,持续深化本科教育教学改革,积极构建创新型人才培养平台,着力培养学生的创新精神和实践能力,为推动学校高质量发展、服务地方经济社会发展培养更多优秀人才。

会上,东北大学资源与土木工程学院赵鑫、沈阳第四人民医院肛肠诊疗中心张勇、辽宁省疾病预防控制中心卫生微生物所王艳、北京君立康生物科技有限公司厉刚、沈阳药科大学生命科学与生物制药学院张怡轩等人作主旨报告。



经过形式审查、初赛函评,优选出60幅优秀作品进行现场决赛。120余人参加现场决赛,最终评选出一等奖50项、二等奖100项,三等奖185项。这些奖项不仅是对创作者将不可见的微生物世界转化为可见艺术之美这一创新能力的肯定,也见证了青年学子在跨学科探索中绽放的无限活力。

每一幅在培养皿中“生长”出的画作,都不仅是科学与艺术的结晶,更是当代青年学子家国情怀与时代担当的生动表达。他们以微生物为墨,以接种环为笔,让原本无形的科学探索,在方寸之间绽放出可见、可感的绚丽光彩,深刻诠释了“生命之美”与“创新之力”的完美融合。
辽宁省普通高等学校本科大学生微生物科学与艺术设计大赛是将前沿科学与艺术创意深度融合,为大学生提供了一个极具特色的创新实践平台,已连续举办五届。赛事通过可视化创作激发学生的科学想象力与美学表达,引导青年在构思、实验到展示的全过程中,综合运用生物学知识与艺术设计,锤炼跨学科思维与实践能力。比赛强调作品原创性与应用潜力,启迪学生思考科学价值与社会意义,初步培育将创意转化为价值的创新与创业潜能。作为培养复合型、创新型人才的重要载体,赛事同步提升学生的科学素养、艺术修养、动手能力与协作精神,为其成长为善于实践、敢于突破的卓越人才奠定基础。
审核校对:倪现朴、高志远、杨奇志、王欣丽、于鹏宇